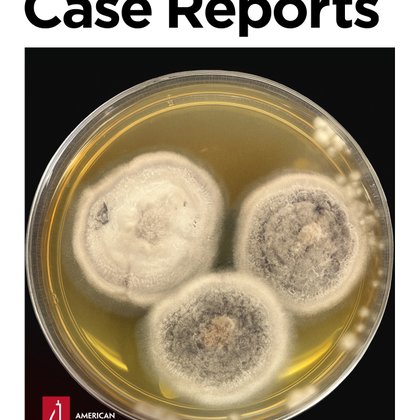
Tweet card summary image

Cole Bredehoeft
@cbredeMD
Followers
198
Following
1K
Media
31
Statuses
159
HIV/ID @OhioState_ID 🦠👨🏻⚕️ • MP4L @OSUMedPedsRes • @MUmedicine & @Mizzou alum 🐯• 🏳️🌈 • @cbredeMD.bsky.social • Views are my own
Columbus, OH
Joined June 2019
Excited to share our experience in diagnosis and treatment of C fetus IE as an OI. Check it out here! https://t.co/4JsDxNHG0m
journals.asm.org
Campylobacter fetus is a gram-negative, non-spore-forming, spiral-shaped bacterium that is composed of two humanly relevant subspecies, including C. fetus subspecies fetus and C. fetus subspecies...
0
0
0
Finally finished with graduations—Excited to be finishing up ID training in a few short weeks! Looking forward to a brief hiatus afterwards with some traveling before joining the amazing group here at @OhioState_ID!
0
1
14
The MEFIER Score - A Risk Score to Stratify Infective Endocarditis in Patients with Enterococcus faecalis bacteremia based on an 11-year territory-wide cohort ✅ Just Accepted ✍️ @CUHKofficial @CUHKMedicine
https://t.co/VQ73C3In15
academic.oup.com
We developed a unique machine learning-derived risk stratification score for Enterococcus faecalis infective endocarditis that can be applied prior to beds
0
16
30
Once-a-year injection to protect against HIV is safe and shows promise as a long-acting prevention medication, phase 1 study finds. Explore the research 👉 https://t.co/Ay65LZ8rmm
5
84
202
"If PEPFAR were to be eliminated during the 90-day review, the world would be faced with a full resurgence of the HIV pandemic by 2029 with an estimated 6.3 million AIDS-related deaths & 3.4 million AIDS orphans within 4 years" 🆕 @jiasociety field notes: https://t.co/dVYescFvBS
2
52
92
If Isiah Pacheco scores a touchdown and the Chiefs win SB LIX, we'll give an Isiah Pacheco autographed jersey to someone who reposts this post and follows us!
115
3K
2K
“This is a matter of life or death,” said @BGrinsztejn, president of the International Aids Society, adding that stopping Pepfar would be disastrous. “If that happens, people are going to die and HIV will resurge.”
theguardian.com
Abrupt order has done ‘serious damage’, say experts, with supply chains halted, HIV clinics struggling to source drugs and refugee camps facing loss of vital services
1
16
36
If Trent McDuffie gets an interception AND the Chiefs beat the Bills tonight, we'll give a Trent McDuffie autographed jersey to someone who reposts this post and follows us!
81
2K
2K
Excited to announce our ID Fellow Class of 2027! Cannot wait to work with these outstanding fellows!!!
0
2
17
While you are anxiously awaiting the new year, we are anxiously awaiting our Ohio State PGY2 ID residency app deadline (1/6) to learn about all the amazing future ID pharmacists! Visit https://t.co/DAWr4umUO1 to learn about interview plans and request 1 on 1 info sessions! 🤗
osupharmacyresidency.com
Visit the post for more.
0
2
14
Excited to share our abstract review featured in the AMJ Microbiology & Infectious Diseases Review of IDWeek 2024! https://t.co/eSCUWvxdxq
emjreviews.com
As persons with HIV (PWH) age, non-AIDS-defining cancers (NADC) are emerging as a leading cause of morbidity and mortality...
0
0
4
Incredibly excited to introduce our match day class of 2024 @OSUWexMed! Excited to see that the future of ID is bright!
0
1
20